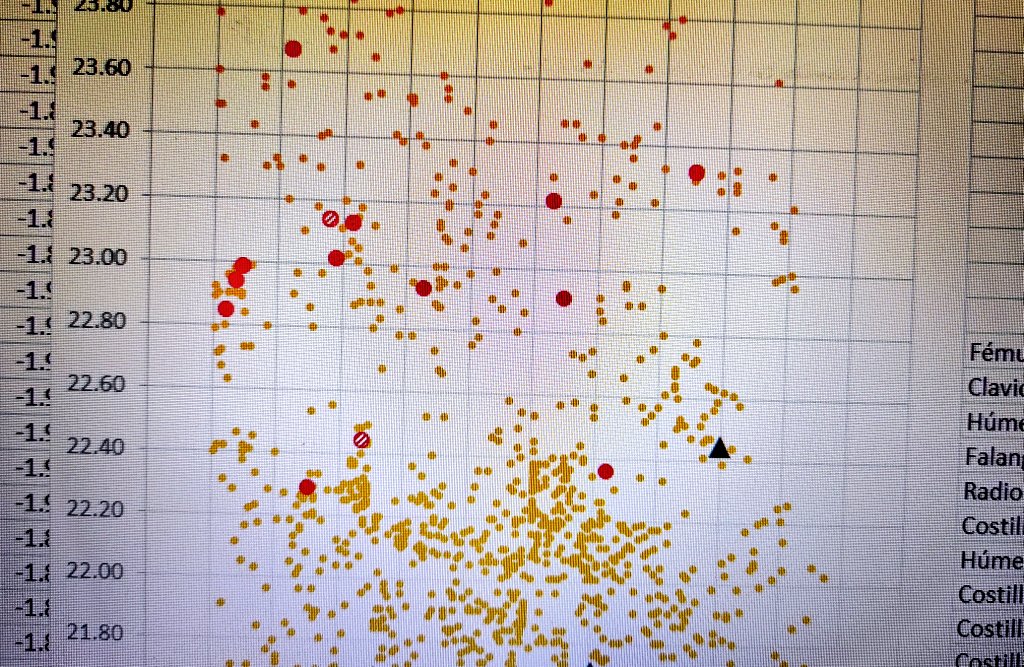
Miguel_preh's tweet image. Sometimes I see points... Points everywhere... #ForensicTaphonomy #Osteoarchaeology

#forensictaphonomy 検索結果
Charlotte Loy, also a PhD Candidate and Demonstrator in Forensic Science, presented a poster on taphonomic staining and environmental impact on bone research. #ForensicTaphonomy

Super excited to be presenting my current research at the @BAFA_info Winter Conference today! Looking forward to learning more about the fantastic research which is being conducted in the UK, especially in #ForensicTaphonomy

With our poster called “Making skull cups: butchering traces on cannibalised human skulls from five European archaeological sites” at the 9th ESHE 2019 Meeting in Liège (Belgium). 💀🔬🧡 #ESHE2019 #archaeology #ForensicTaphonomy #skullcups #Iphes @iphes

@MaikenLand presenting her insights on the future of #forensictaphonomy at the joint @ANZFSS_NSW and UTS FSS end of year event

#ForensicTaphonomy #MedicolegalCases #MedicolegalDeathInvestigations #TaphonomicChanges #TheForensicPosts #TFP #CSI

#ForensicTaphonomy #TissueDecomposition #ScavengerActivity #CriminalInvestigations #ForensicScience #ForensicsMonday #TheForensicPosts #TFP #CSI

#ForensicTaphonomy #DecompositionRate #InsectActivity #Forensics #ForensicInvestigation #TheForensicPosts #ForensicsMonday #TFP #CSI

Enjoyed listening to @Brooksy_Jonno present his thoughts on advances in #forensictaphonomy, #decomposition biochemistry (and bananas) as part of @ANZFSS_WA webinar series tonight. Such an engaging and informative presentation!

Yesterday it was a bit more santa claws 🐾 than Santa Claus 🎅🏽 as our students examined 🔬 the entomological species and remains 💀of their #forensictaphonomy research projects (🐇) #teachingthroughresearch



This afternoon the #MScForensicScience students were learning all things #ForensicTaphonomy with our very own @Brooksy_Jonno. Always great to see #Casework and #Reseach informing #Teaching. Thank you! ☠🕵🏻♂️👨🔬 @KingsForensics @Kings_SPHES #ForensicFriday

Let's start preparing the presentation for my oral communication at the #EAA2021 @archaeologyEAA, on #ForensicTaphonomy and its application in prehistoric commingled human accumulations. 😁💀 First step: cover page!

The bound copy of my thesis has arrived 😀 Of course it will never be opened in case I find a typo! #phd #forensictaphonomy



Charlotte Loy, also a PhD Candidate and Demonstrator in Forensic Science, presented a poster on taphonomic staining and environmental impact on bone research. #ForensicTaphonomy

3/3..environmental interactions closely mirror those observed in human remains #ForensicTaphonomy #ForensicEntomology #DeathInvestigations
#ForensicTaphonomy #DecompositionRate #InsectActivity #Forensics #ForensicInvestigation #TheForensicPosts #ForensicsMonday #TFP #CSI

#ForensicTaphonomy #TissueDecomposition #ScavengerActivity #CriminalInvestigations #ForensicScience #ForensicsMonday #TheForensicPosts #TFP #CSI

Our Research Centre for Field Archaeology and Forensic Taphonomy involves collaborations with leading national and international organisations. 🦴 Find out more 👇 ow.ly/2EOc50Rtsjx #Archaeology #ForensicTaphonomy

Researchers at @TheBodyFarm_UTK noticed donated human bodies decomposing at different rates, despite identical conditions. Their NIJ-supported study revealed how different drugs altered decomposition, which could change time-of-death estimates. Read more: nij.ojp.gov/topics/article…

Professr Sayer launching our exciting #Research Institute for Materials and Investigative Science, where field #archaeology, #forensictaphonomy, #smartmaterials, #fire, #hazard, #forensic, #DNA, #chemistry and #anthropology researchers are doing amazing work @UCLanResearch

#ForensicTaphonomy #MedicolegalCases #MedicolegalDeathInvestigations #TaphonomicChanges #TheForensicPosts #TFP #CSI

Here it is, my daughter! 🎉 Less than two weeks left for the #PhD oral defense at @iphes, let's make the last push! 💪🏼 I studied two #CollectiveBurials 💀 from a #ForensicTaphonomy perspective 🔬, including #Taphonomy #FuneraryPractices #Paleopathology and #PrehistoricViolence 😁

How it started, and how it ended! Afternoon of doing figures for thesis' Results section 👌🏼💃🏼. These are some congenital anomalies, such as transitional vertebrae, spina bifica occulta, or a case of patella bipartita. #Paleopathology #ForensicTaphonomy #Chalcolithic #RocOrenetes




The bound copy of my thesis has arrived 😀 Of course it will never be opened in case I find a typo! #phd #forensictaphonomy



Interpersonal violence is one of the topics of my thesis on Prehistoric #ForensicTaphonomy 💀. It is present during all periods, but during the #Neolithic it is very common to find evidence of violence in the osteoarchaeological record. "Did you steal my cow? I'll kill you!"
Anybody know a reviewer or would be willing to review a short paper? #Forensictaphonomy #taphonomy #zooarchaeology
Haha I'm always pulling some sort of weird face 🤣 Thanks to all those who listened to my presentation today and provided me kind words after at the @CharterForSci #ForensicConference Such a great day to be updated with #forensictaphonomy research ☠️
Hello, would you like to do a PhD with me? There will be bones 🦴💀, burials 🍂🦠 and 3D biomedical imaging 🖥️🔬 #ForensicTaphonomy #ForensicAnthropology #ForensicImaging
❗️PhD Studentship News❗️ 2x Fully funded PhD studentships @KeeleFATAL @keeleforensics with @AmberJCollings and @ChrisJDAris. International applicants welcome. Deadline 31st January 2023. Links and more info in attached thread.
It's finally happened. I'm analysing the last sample for my research #phd #forensictaphonomy #research

#ForensicTaphonomy #MedicolegalCases #MedicolegalDeathInvestigations #TaphonomicChanges #TheForensicPosts #TFP #CSI

#ForensicTaphonomy #TissueDecomposition #ScavengerActivity #CriminalInvestigations #ForensicScience #ForensicsMonday #TheForensicPosts #TFP #CSI

#ForensicTaphonomy #DecompositionRate #InsectActivity #Forensics #ForensicInvestigation #TheForensicPosts #ForensicsMonday #TFP #CSI

Pokines & Pollock examine the role of small #scavengers and the high potential for their involvement in the #scavenging of human skeletal remains in exposed terrestrial environments. Read about their research: journals.upress.ufl.edu/fa/article/vie… #forensictaphonomy #forensics #taphonomy

Charlotte Loy, also a PhD Candidate and Demonstrator in Forensic Science, presented a poster on taphonomic staining and environmental impact on bone research. #ForensicTaphonomy

With our poster called “Making skull cups: butchering traces on cannibalised human skulls from five European archaeological sites” at the 9th ESHE 2019 Meeting in Liège (Belgium). 💀🔬🧡 #ESHE2019 #archaeology #ForensicTaphonomy #skullcups #Iphes @iphes

Super excited to be presenting my current research at the @BAFA_info Winter Conference today! Looking forward to learning more about the fantastic research which is being conducted in the UK, especially in #ForensicTaphonomy

Our FS 460 (Forensic Taphonomy) students have been busy learning to collect insects! Entomology is used in Forensic Science to help estimate postmortem interval (PMI). #forensictaphonomy #fieldwork #handsonforensics


Some hungry carnivores have been here... 😏🐺💀 #RocDeLesOrenetes #RocOrenetes #ForensicTaphonomy #CollectiveBurial #BronzeAge #Scapula #CarnivoreModification

@MaikenLand presenting her insights on the future of #forensictaphonomy at the joint @ANZFSS_NSW and UTS FSS end of year event

Looking some small taphonomic modifications on human bones is a good plan for a Friday afternoon! #FossilFriday #ForensicTaphonomy #RocOrenetes #Chalcolithic #BronzeAge #CollectiveBurial #HIROXMicroscope

Super happy for our study that appears on the cover of Atapuerca's journal💀📊📈 #SkullCups #Cannibalism #ForensicTaphonomy #GIS #Atapuerca #TD6 #GoughsCave #Fontbrégoua #Herxheim #ElMirador kiosko.atapuerca.org/Ejemplar/59203

Something went wrong.
Something went wrong.
United States Trends
- 1. Texans 24.1K posts
- 2. James Cook 3,984 posts
- 3. #MissUniverse 47.4K posts
- 4. Sedition 224K posts
- 5. #TNFonPrime 1,296 posts
- 6. Christian Kirk 2,308 posts
- 7. Will Anderson 2,368 posts
- 8. Lamelo 9,363 posts
- 9. Prater N/A
- 10. Treason 119K posts
- 11. Cheney 103K posts
- 12. Shakir 2,764 posts
- 13. #Bills 1,929 posts
- 14. Paul George 1,942 posts
- 15. #htownmade 1,166 posts
- 16. TMNT 6,098 posts
- 17. Seditious 125K posts
- 18. Jalen Suggs N/A
- 19. Commander in Chief 64.4K posts
- 20. #BUFvsHOU 1,371 posts